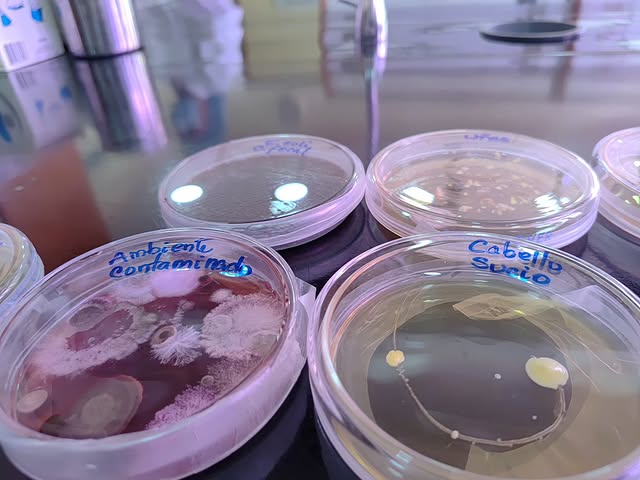
ciepe.estudiantes3

(Caracas, 29 de octubre de 2025).– Un total de 26 jóvenes del Complejo Educativo Eugenio Leopoldo Tacoa Barráez, ubicado en el municipio Cocorote, estado Yaracuy, participó en una enriquecedora jornada del Programa Nacional Semilleros Científicos, organizada por la Fundación Centro de Investigaciones del Estado para la Producción Experimental Agroindustrial (Ciepe).
Durante la visita, los estudiantes de tercero, cuarto y quinto años de educación media realizaron un recorrido guiado por los laboratorios de las divisiones de físico-química, biotecnología y microbiología.
Los jóvenes exploraron diferentes aspectos científicos, observando procesos como la determinación de la acidez en frutas y sus derivados, y conociendo el mundo de los microorganismos y bacterias.
El propósito de esta iniciativa es despertar el interés temprano por la ciencia, fomentando vocaciones científicas mediante experiencias prácticas y motivadoras, orientando a la juventud hacia la generación de relevo en el conocimiento.
Con esta actividad, el Ministerio del Poder Popular para Ciencia y Tecnología (Mincyt), reafirma su compromiso con el vértice uno de la Gran Misión Ciencia, Tecnología e Innovación Dr. Humberto Fernández-Morán, dentro del Plan de Masificación de las Rutas Científicas.
Prensa/Mincyt/Con información del Ciepe